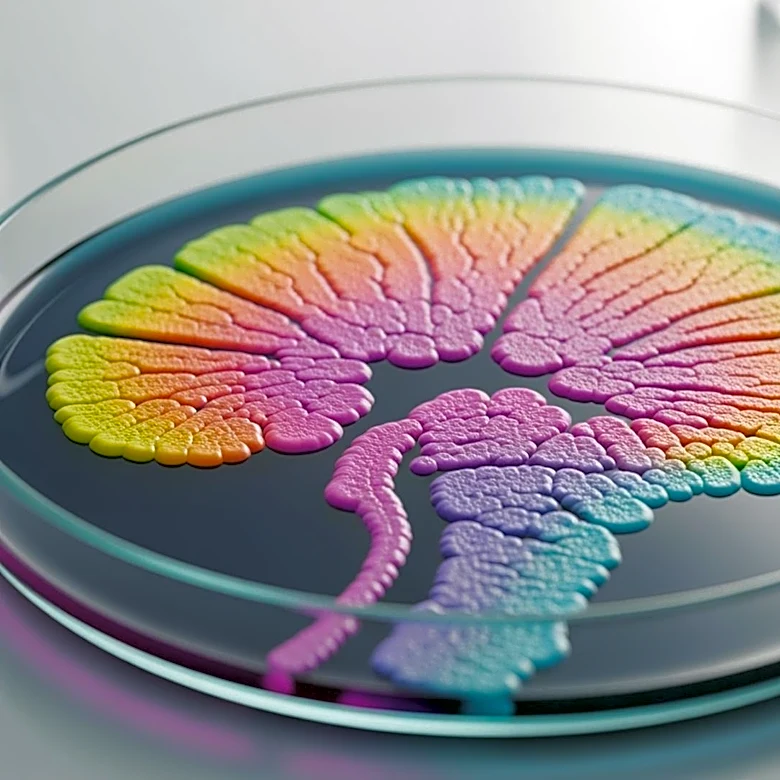
Researchers Explore Microbiome's Influence on Dietary Preferences in Mice

Cognitive control is a fascinating aspect of human psychology that involves the regulation of thoughts and actions to achieve specific goals. It is a crucial component of executive functions, primarily managed by the prefrontal cortex of the brain. This article delves into the intricacies of cognitive control, highlighting its significance in everyday life and its underlying mechanisms.
The Role of Cognitive Control
Cognitive control is often described as the ability to control one's
thoughts and actions. This ability is essential for maintaining focus, making decisions, and inhibiting impulses that may interfere with goal-directed behavior. It allows individuals to prioritize tasks, manage distractions, and adapt to changing circumstances. The prefrontal cortex plays a pivotal role in these processes, acting as the brain's command center for executive functions.
One of the key aspects of cognitive control is attentional control, which involves the ability to focus on relevant information while ignoring distractions. This skill is vital in various situations, such as studying for an exam or driving in heavy traffic. Inhibition, another component of cognitive control, refers to the ability to suppress automatic or habitual responses in favor of more appropriate actions. This is crucial for self-regulation and impulse control.
Mechanisms of Cognitive Control
The mechanisms underlying cognitive control are complex and involve various neural processes. The prefrontal cortex is responsible for maintaining and updating task goals, as well as inhibiting irrelevant information. This region of the brain is highly interconnected with other areas, allowing for the integration of sensory input, memory, and emotional responses.
Research has shown that cognitive control is developed through reinforcement and learning from previous experiences. This development allows individuals to become more flexible in their ability to choose between conflicting stimuli. Tasks such as the Stroop color-word task and the Eriksen flanker task are commonly used to assess cognitive control, as they require participants to manage competing information and make quick decisions.
Challenges and Quirks of Cognitive Control
Despite its importance, cognitive control is not infallible. One interesting phenomenon is ironic rebound, where attempts to suppress a particular thought result in that thought becoming more prevalent. This highlights the challenges of maintaining cognitive control, especially under stress or time pressure.
Moreover, cognitive control can be influenced by various factors, including stress, fatigue, and emotional states. These factors can impair the brain's ability to regulate thoughts and actions, leading to difficulties in decision-making and impulse control. Understanding these challenges can help individuals develop strategies to enhance their cognitive control and improve their overall executive functioning.
In conclusion, cognitive control is a vital aspect of human psychology that enables individuals to regulate their thoughts and actions effectively. By understanding its mechanisms and challenges, we can better appreciate the complexity of the brain's executive functions and their impact on our daily lives.